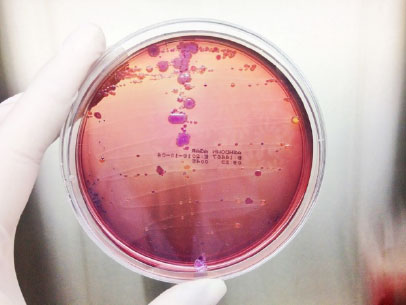
limitations of standard urine cultures

Given that post-operative urinary tract infections can be common after urologic stone surgery, prophylactic antibiotics are typically given to patients before their ureteroscopic lithotripsy (URSL) procedure to break up urologic stones as a standard of care. The administration of antimicrobial prophylaxis is primarily based on prior urinalysis or urine culture results in accordance with the AUA/Endourology Society Guideline for Surgical Management of Kidney Stones.
Additionally, several studies show the effectiveness of prophylactic treatment. In a study published in the BJUI, pre-operative prophylactic antibiotics were shown to be successful in reducing bacteriuria, therefore reducing the risk of post-operative infections at the surgical sites.1
However, according to a paper published by the Open Journal of Urology, a group of researchers at the University of Texas Health at Austin recently revealed that even when patients have culture-negative urine before URSL procedures, microbes such as Citrobacter and Veillonella atypica, as well as fungi Candida albicans, were detected in the patients pre-surgery via MicroGenDx’s next-generation sequencing (NGS) DNA diagnostic testing.2
Could the standardized use of next-generation sequencing prior to URSL procedures lead to more patient-centric and personalized prophylactic antibiotic regimens, further reducing the incidence of post-operative infection? The use of next-generation sequencing in these patients also detected the presence of antibiotic-resistance genes — information that can certainly alter a surgeon’s prophylactic treatment plan.
Ureteroscopic Lithotripsy (URSL) and Post-Operative Infections
Ureteroscopic lithotripsy is a surgical technique that has been increasingly popular among patients with ureteral or renal stones due to its minimally invasive nature and high success rate.3 However, urinary tract infections (UTIs) were reported to be the most frequent post-surgery complications. Infections can be caused by instrumentation, but most commonly are expected to be from microbes already present in the patient’s urinary tract or harbored within stone material itself.
One study revealed that even though prophylactic antibiotics are routinely given to patients before the procedure, febrile UTIs (fUTIs) still occurred in about 15% of patients.3 A systemic review study concluded that while patients who received prophylactic antibiotics had lower rates of fUTIs, the reduced rates were not statistically significant.4
Limitations of Standard Urine Cultures
While prophylactic antibiotics can substantially reduce pre-operative pyuria and bacteriuria,1,4 a proportion of patients still develop fUTIs after undergoing URSL. What exactly is causing this discrepancy? The limitations of standard urine cultures could account for this difference. In the aforementioned University of Texas study, the urine cultures were only successful in identifying bacteria in 11 percent of the patients.2 Furthermore, according to a study published in the Journal of Endourology, many patients who developed post-URSL fUTIs showed negative culture results, both pre- and post-operatively.5
While prophylactic antibiotics can substantially reduce pre-operative pyuria and bacteriuria,1,4 a proportion of patients still develop fUTIs after undergoing URSL. What exactly is causing this discrepancy? The limitations of standard urine cultures could account for this difference. In the aforementioned University of Texas study, the urine cultures were only successful in identifying bacteria in 11 percent of the patients.2 Furthermore, according to a study published in the Journal of Endourology, many patients who developed post-URSL fUTIs showed negative culture results, both pre- and post-operatively.5
Two significant limitations of standard urine cultures include:
- Low sensitivity rate
- Selective bias: Standard culture dishes are not suited to culture certain ‘atypical’ microbes, fungus, and anaerobic micro-organisms.
Next-Generation Sequencing a More Accurate Diagnostic Tool
 Using a more sensitive and accurate DNA diagnostic methodology, next-generation sequencing DNA diagnostic testing, the researchers were able to detect the presence of bacterial and fungal populations in the culture-negative urine samples.1 Next-generation sequencing (NGS) is a process of high-throughput sequencing of nucleic acids of all microbes, including aerobic and anaerobic bacteria, atypical bacterial species, and fungi.
Using a more sensitive and accurate DNA diagnostic methodology, next-generation sequencing DNA diagnostic testing, the researchers were able to detect the presence of bacterial and fungal populations in the culture-negative urine samples.1 Next-generation sequencing (NGS) is a process of high-throughput sequencing of nucleic acids of all microbes, including aerobic and anaerobic bacteria, atypical bacterial species, and fungi.
All detectable DNA are sequenced and matched to a database of over 50,000 known species, eliminating the need for an organism to grow in a culture media under artificial conditions, as in standard urine culture. Genetic antibiotic-resistance information is also detectable on a sample specific level. Polymicrobial infections are reported at the species level, not discarded as a contaminated or “mixed-flora” sample without identification of individual organisms.
MicroGenDX qPCR+NGS Diagnostics Can Close the Culture Gap
Despite the routine administration of prophylactic antibiotics prior to URSL procedures, and often negative pre-operative urine cultures, a significant portion of patients develop post-operative infections including fUTI. Even patients with signs or symptoms of UTI have negative pre-operative and post-operative cultures.
This discrepancy could lead to the development of more severe infection and may require the use of empiric antibiotic therapy when the option for patient specific directed antibiotic therapy exists.
A more accurate diagnostic solution such as the qPCR+NGS provided by MicroGenDX can bridge that gap. By combining two advanced technologies, MicroGenDX can provide rapid and in-depth screening of microbial DNA sequences within three to five business days. MicroGenDX’s report includes the identities of the microbes as well as sample-specific genetic resistance information so that clinicians can make informed and personalized decisions regarding antibiotic prophylaxis for patients undergoing URSL.
By sequencing patients’ urine samples pre-URSL, the prophylactic antibiotics can be modified or even customized to ensure that the microbes present in individual patients were adequately treated before URSL. If patients develop UTI post-operatively, their urine samples can again be sequenced, and the appropriate treatments can be administered. MicroGenDX’s qPCR+NGS can improve not only current standard procedures for URSL but also antibiotic stewardship and the quality of patient care.
Resources
[1] https://bjui-journals.onlinelibrary.wiley.com/doi/10.1111/bju.12502
[2] https://www.scirp.org/journal/paperinformation.aspx?paperid=110811
[3] https://icurology.org/DOIx.php?id=10.4111/icu.2018.59.5.335
[4] https://www.liebertpub.com/doi/abs/10.1089/sur.2014.013?journalCode=sur



